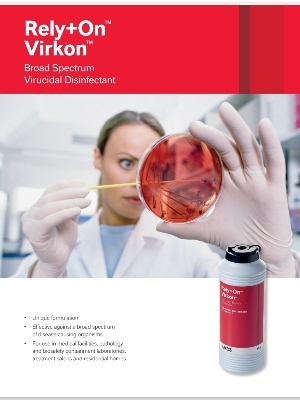
Rely+On Virkon High Level Disinfectant Grade: Medical

Instrument Disinfectant - Glutaraldehyde Solution 2% & 2.45% W/v, White, 5 Liters Plastic Jug | Broad Spectrum, Fast Acting, Long Lasting, Reliable
Price:
Get Latest Price
In Stock
Product Specifications
| Color | White |
| Composition | Glutaraldehyde |
| Concentration | 2% & 2.45% |
| Volume | 5 Liters |
| Packaging | Plastic Jug |
| Shelf life | 14 days |
| Application | Instruments |
| Features | Fast acting, Long lasting, Broad spectrum, Effective, Safe, Reliable, Cost effective |
Product Overview
Key Features
Strumen Instrument Disinfectant is a latest innovation in instrument disinfectant. This is a standard instrument disinfectant that remains active for 14 days. This is highly reliable solution for treatment of contaminated instruments and keeping the patients protected from any kind of infection. The mechanism allows 100% removal of contaminated elements found in the instruments that may infect the patients undergoing surgery. Being a trusted supplier, wholesaler and distributor, we offer Strumen Instrument Disinfectant at highly competitive price. Bulk buyers are most welcome.
Composition:
- Strumen 2% & 2.45% Contains
- Glutaraldehyde Solution 2.45% w/v with liquid activator
- Glutaraldehyde Solution 2% w/v with liquid activator
Application Areas:
Ideal for disinfection and sterilization of:
- Rigid and flexible endoscopes
- Diamond cutting burs, root canal and hand set instruments
- Instruments made of metal, plastic, porcelain glass, ceramics, stainless steel and rubber
Company Details
Business Type
Importer, Service Provider, Distributor, Supplier
Employee Count
50
Establishment
2015
Working Days
Monday To Saturday
GST NO
36AAKFC1055F1ZQ
Related Products
Explore Related Categories
More Products From This Seller
Seller Details
GST - 36AAKFC1055F1ZQ
Hyderabad, Telangana
Accepts only Domestic inquiries
Partner
Mr. Hardeep Kumar
Address
Citron Scientific Block B, Survey No. 156, 157 & 174, Dhullapally Road, Kompally, Hyderabad, Telangana, 500014, India
Report incorrect details